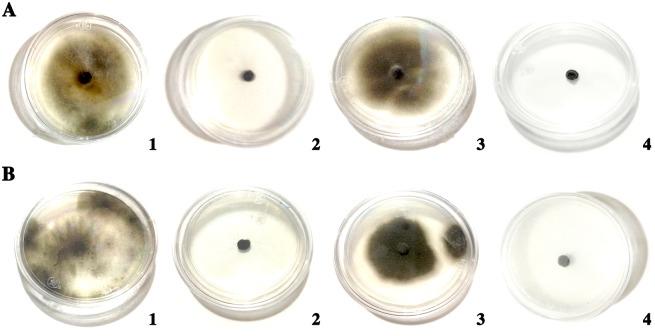
https://cdn.ncbi.nlm.nih.gov/pmc/blobs/8b62/5283677/da318ffa825e/pone.0170782.g006.jpg

枝孢菌和拟枝孢菌作为菊白锈病病原菌——禾柄锈菌潜在的新型真菌拮抗菌。
Cladosporium cladosporioides and Cladosporium pseudocladosporioides as potential new fungal antagonists of Puccinia horiana Henn., the causal agent of chrysanthemum white rust.
作者信息
Torres David Eduardo, Rojas-Martínez Reyna Isabel, Zavaleta-Mejía Emma, Guevara-Fefer Patricia, Márquez-Guzmán G Judith, Pérez-Martínez Carolina
机构信息
Instituto de Fitosanidad, Colegio de Postgraduados, Montecillo, Texcoco, México.
Departamento de Ecología y Recursos Naturales, Facultad de Ciencias, Universidad Nacional Autónoma de México, Ciudad de México, Distrito Federal, México.
出版信息
PLoS One. 2017 Jan 31;12(1):e0170782. doi: 10.1371/journal.pone.0170782. eCollection 2017.
Puccinia horiana Hennings, the causal agent of chrysanthemum white rust, is a worldwide quarantine organism and one of the most important fungal pathogens of Chrysanthemum × morifolium cultivars, which are used for cut flowers and as potted plants in commercial production regions of the world. It was previously reported to be controlled by Lecanicillium lecanii, Cladosporium sphaerospermum, C. uredinicola and Aphanocladium album, due to their antagonistic and hyperparasitic effects. We report novel antagonist species on Puccinia horiana. Fungi isolated from rust pustules in a commercial greenhouse from Villa Guerrero, México, were identified as Cladosporium cladosporioides and Cladosporium pseudocladosporioides based upon molecular analysis and morphological characters. The antagonism of C. cladosporioides and C. pseudocladosporioides on chrysanthemum white rust was studied using light and electron microscopy in vitro at the host/parasite interface. Cladosporium cladosporioides and C. pseudocladosporioides grew towards the white rust teliospores and colonized the sporogenous cells, but no direct penetration of teliospores was observed; however, the structure and cytoplasm of teliospores were altered. The two Cladosporium spp. were able to grow on media containing laminarin, but not when chitin was used as the sole carbon source; these results suggest that they are able to produce glucanases. Results from the study indicate that both Cladosporium species had potential as biological control agents of chrysanthemum white rust.
菊白锈病菌(Puccinia horiana Hennings)是一种全球检疫性生物,也是菊属(Chrysanthemum × morifolium)栽培品种最重要的真菌病原体之一,这些栽培品种在世界商业生产地区用于切花和盆栽植物。此前有报道称,由于其拮抗和重寄生作用,淡紫拟青霉(Lecanicillium lecanii)、球形枝孢(Cladosporium sphaerospermum)、锈生枝孢(C. uredinicola)和白绒拟枝孢(Aphanocladium album)可对其进行控制。我们报道了菊白锈病菌的新型拮抗物种。从墨西哥格雷罗将军镇一个商业温室的锈斑中分离出的真菌,经分子分析和形态特征鉴定为枝状枝孢(Cladosporium cladosporioides)和假枝状枝孢(Cladosporium pseudocladosporioides)。利用光学显微镜和电子显微镜在体外宿主/寄生物界面研究了枝状枝孢和假枝状枝孢对菊白锈病的拮抗作用。枝状枝孢和假枝状枝孢向菊白锈病菌冬孢子生长并定殖于产孢细胞,但未观察到冬孢子被直接穿透;然而,冬孢子的结构和细胞质发生了改变。这两种枝孢属真菌能够在含有海带多糖的培养基上生长,但以几丁质作为唯一碳源时则不能生长;这些结果表明它们能够产生葡聚糖酶。研究结果表明,这两种枝孢属真菌都有潜力作为菊白锈病的生物防治剂。